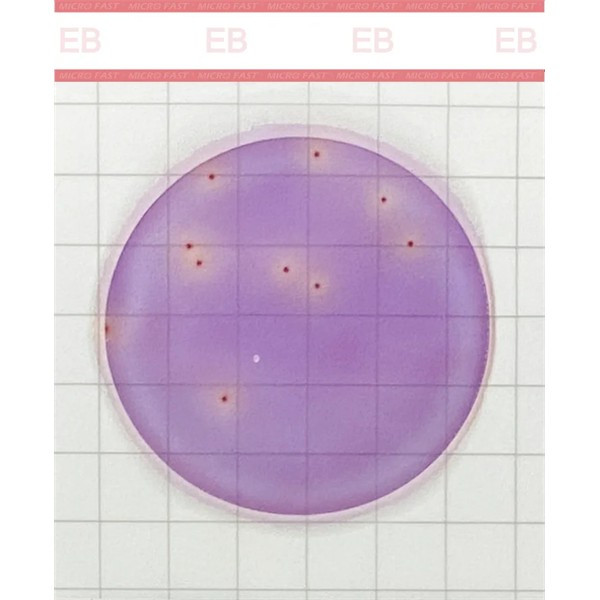
Perkin Elmer count plate

Frequently bought together:
Description
MicroFast® Enterobacteriaceae Count Plate (EB) is a sample-ready-culture medium system. It uses innovative
technologies such as new-generation microbial coloration to achieve rapid proliferation and interpretation of colonies,
greatly improving the detection efficiency in the laboratory. Provides results in less than 24 hours.
The plate contains a prefabricated type of medium, cold water gel, and indicator. It is intended for the enumeration of
Enterobacteriaceae in food and environmental samples.